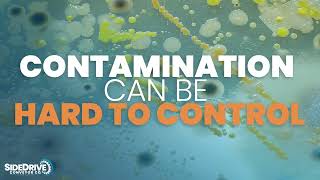

SideDrive Conveyor Company, an NCC Company, provides completely configurable and
modular sanitary side drive conveyor solutions. Protect product quality and improve your
operations with a unique plastic modular belting technology that creates a smooth and effortless
motion. SideDrive Conveyor meets the highest sanitary requirements and offers the ultimate in
flexibility. With side drive technology, the configurations are limitless and the possibilities are
endless. SideDrive Conveyor is the first and only company in the world focused solely on
configurable side drive conveyor solutions. As an employee-owned company, SideDrive
Conveyor is committed to providing and integrating a quality transport system that works for
you. Visit www.sidedriveconveyor.com for more information.
Shared 1 year ago
58 views
Shared 1 year ago
562 views
Shared 1 year ago
23 views
Shared 1 year ago
74 views
Shared 1 year ago
56 views
Shared 3 years ago
38 views
Shared 3 years ago
96 views
Shared 3 years ago
74 views
Shared 4 years ago
255 views